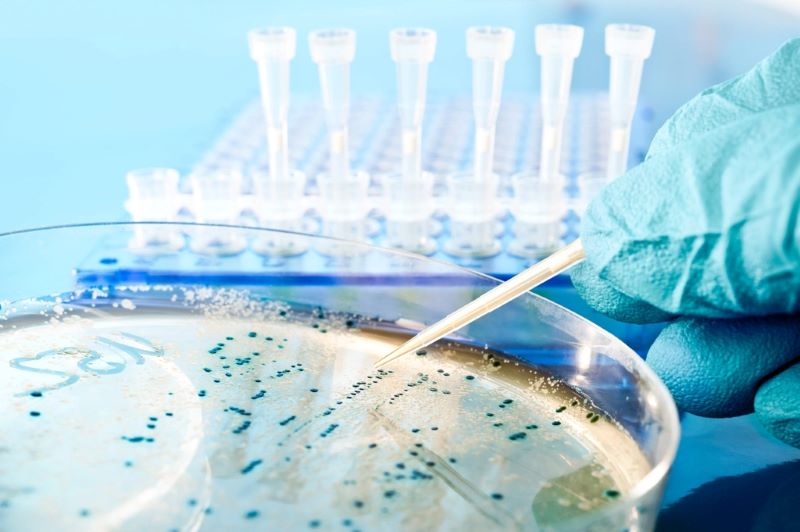

Công nghệ sinh học là gì? Lĩnh vực ứng dụng và vai trò của công nghệ sinh học
Công nghệ sinh học là một trong những lĩnh vực sinh học rộng lớn, được nghiên cứu và ứng dụng ngày càng nhiều để tạo ra các sản phẩm cần thiết cho đời sống con người. Trong bài viết này, Geneworld sẽ giúp bạn giải đáp về khái niệm “công nghệ sinh học là gì” cũng như tất tần tật những ứng dụng và vai trò của công nghệ sinh học, khám phá ngay thôi nào!
Công nghệ sinh học là gì?
Về khái niệm, công nghệ sinh học là ngành công nghệ sử dụng các tế bào sống, dựa trên quá trình sinh học để khai thác các kiến thức và phát triển các sản phẩm sinh học nhằm hỗ trợ cải thiện cuộc sống, sức khỏe.
Nói cách khác, công nghệ sinh học là một lĩnh vực công nghệ cao xây dựng trên cơ sở lý thuyết về sự sống với sự phối hợp giữa quy trình nghiên cứu cùng trang thiết bị kỹ thuật nhằm tạo nên các sản phẩm sinh học chất lượng cao. Các sản phẩm này sẽ đáp ứng được yêu cầu và lợi ích của con người trong nền kinh tế – xã hội và cung cấp sản phẩm thân thiện với môi trường, đồng thời giảm thiểu tình trạng ô nhiễm môi trường hiện nay.
>>Xem thêm: Công nghệ tế bào gốc là gì? Ứng dụng tế bào gốc trong làm đẹp

Vai trò của công nghệ sinh học
Công nghệ sinh học hiện đại được ứng dụng để đem đến các sản phẩm điều trị mang tính đột phá và những công nghệ mới giải quyết được các vấn đề thường nhật. Bên cạnh đó, sản phẩm ứng dụng công nghệ sinh học giảm tác động đến môi trường, chống nạn đói, sử dụng ít năng lượng và sạch hơn. Đồng thời lĩnh vực công nghệ này cũng giúp quy trình sản xuất công nghiệp trở nên an toàn và hiệu quả hơn rất nhiều.

Các lĩnh vực nào ứng dụng công nghệ sinh học?
Danh sách các lĩnh vực tiềm năng cho công nghệ sinh học gần như vô tận. Để tổ chức và phân biệt các lĩnh vực công nghệ sinh học này, các nhà khoa học đã nỗ lực nghiên cứu và phân loại các lĩnh vực theo màu sắc, bao gồm:
- Công nghệ sinh học đỏ: Công nghệ sinh học y tế
- Công nghệ sinh học xanh lá: Công nghệ sinh học môi trường tập trung vào nông nghiệp
- Công nghệ sinh học xanh da trời: Công nghệ sinh học biển
- Công nghệ sinh học trắng: Công nghệ sinh học ứng dụng trong công nghiệp
- Công nghệ sinh học vàng: Công nghệ sinh học sản xuất thực phẩm
- Công nghệ sinh học xám: Xử lý sinh học và cải thiện môi trường bằng cách sử dụng các sinh vật sống
- Công nghệ sinh học nâu: Công nghệ sinh học sa mạc
- Công nghệ sinh học tím: Các vấn đề pháp lý, đạo đức và triết học trong công nghệ sinh học
- Công nghệ sinh học tối: Vũ khí sinh học và chiến tranh
Tất cả các nhánh của công nghệ sinh học (ngoại trừ công nghệ sinh học tối) đều đang được chú trọng nghiên cứu nhằm cải thiện và xây dựng cuộc sống con người bền vững hơn.

Thành tựu ứng dụng công nghệ sinh học trong đời sống
Công nghệ sinh học đối với nông nghiệp
Công nghệ sinh học có khả năng làm tăng sức đề kháng của cây trồng đối với côn trùng, tăng khả năng chống chịu của cây trồng đối với thuốc diệt cỏ và tạo điều kiện thuận lợi cho việc sử dụng các biện pháp canh tác bền vững với môi trường hơn. Cụ thể, thành tựu của công nghệ sinh học đối với nông nghiệp là:
- Tăng năng suất cây trồng với chi phí đầu vào ít hơn.
- Giảm lượng hóa chất nông nghiệp.
- Cây trồng công nghệ sinh học cần ít thuốc trừ sâu hơn và giảm được các hoạt động canh tác khác như cày bừa, làm đất,...
- Phát triển các loại cây trồng có hàm lượng dinh dưỡng cao, giải quyết tình trạng thiếu hụt vitamin và chất dinh dưỡng.
- Sản xuất thực phẩm không chứa chất gây dị ứng và độc tố.
- Tăng hàm lượng dầu trong thực phẩm và cây trồng, giúp cải thiện sức khỏe tim mạch.

Công nghệ sinh học đối với công nghiệp
Công nghệ sinh học sử dụng các quá trình sinh học như lên men, sử dụng các chất xúc tác sinh học và các vi sinh vật khác để trở thành các nhà máy sản xuất vi mô. Thành tựu của công nghệ sinh học đối với công nghiệp bao gồm:
- Giảm các bước trong quy trình sản xuất hóa chất từ 80% trở lên.
- Giảm nhiệt độ giặt quần áo, tiết kiệm 4,1 tỷ USD hàng năm.
- Cải thiện hiệu quả quy trình sản xuất, tiết kiệm từ 50% chi phí vận hành.
- Giảm sử dụng và phụ thuộc vào hóa dầu.
- Giảm phát thải khí nhà kính từ 52% trở lên khi sử dụng nhiên liệu sinh học.
- Giảm sử dụng nước và phát sinh chất thải.
- Khai thác toàn bộ tiềm năng của các chất thải sinh khối truyền thống.

Công nghệ sinh học trong y dược
Công nghệ sinh học hiện đại cung cấp các sản phẩm và công nghệ đột phá để chống lại các bệnh suy nhược. Các loại thuốc và phương pháp chữa trị cải tiến giúp mọi người sống lâu hơn, khỏe mạnh hơn và tác động tích cực đến xã hội, từ đó:
- Giảm tỷ lệ mắc các bệnh truyền nhiễm.
- Cứu sống hàng triệu trẻ em.
- Thay đổi tỷ lệ mắc các bệnh nghiêm trọng.
- Giảm thiểu nguy cơ về sức khỏe và tác dụng phụ của thuốc.
- Tạo ra các công cụ phát hiện bệnh chính xác hơn.
- Chống lại các bệnh nghiêm trọng và các mối đe dọa hàng ngày mà thế giới đang phải đối mặt.
>>Xem thêm: Ứng dụng của công nghệ tế bào gốc trong y học
Công nghệ sinh học trong làm đẹp
Công nghệ sinh học là một khái niệm tương đối mới trong lĩnh vực làm đẹp. Tuy nhiên, công nghệ này ngày càng được nhiều chuyên gia đánh giá cao về hiệu quả chăm sóc da tối ưu. Công nghệ sinh học được ứng dụng để tạo ra nhiều thành phần dưỡng da phổ biến như axit hyaluronic, collagen, chất bảo quản tự nhiên hay các sản phẩm lên men từ hệ vi sinh Microbiome.
Khác với cách chăm sóc da truyền thống chỉ tập trung vào bề mặt da, chăm sóc da sinh học cho rằng các vấn đề về da là do các vấn đề của tế bào từ sâu bên trong, sự lão hóa da của mô da chính là sự lão hóa của tế bào. Vì vậy, các mỹ phẩm sinh học chăm sóc da thường tập trung cải thiện sự phát triển của da ở cấp độ phân tử, tái cấu trúc các chức năng sinh lý của da.
>> Xem thêm:
Mỹ phẩm sinh học là gì? Có tốt không?
Sản phẩm organic là gì? Lợi ích và cách nhận biết sản phẩm hữu cơ

Các sản phẩm mỹ phẩm ứng dụng nghiên cứu công nghệ sinh học
Người tiêu dùng giờ đây không chỉ muốn các sản phẩm làm đẹp, chăm sóc da an toàn, lành tính mà còn phải thân thiện và bảo vệ môi trường. Các sản phẩm ứng dụng nghiên cứu công nghệ sinh học là giải pháp lý tưởng để tạo ra các thành phần làm đẹp tinh khiết, hiệu suất cao đồng thời bảo đảm an toàn.
Geneworld là hãng mỹ phẩm sinh học tập trung sản xuất các dòng sản phẩm công nghệ cao thuộc lĩnh vực công nghệ sinh học và Y sinh học được nhiều nhà nghiên cứu trong ngành đánh giá cao.
"Luôn đặt lợi ích của khách hàng làm trung tâm của mọi nỗ lực nghiên cứu, sản xuất và kinh doanh" chính là định hướng và châm ngôn hoạt động của Geneworld. Công nghệ sinh học là “công thức chính” tạo nên các sản phẩm chăm sóc, điều trị và dưỡng da lành tính, hoàn toàn từ thiên nhiên. Một số mỹ phẩm chăm sóc da công nghệ sinh học của Geneworld như:
- Kem chống nắng phổ rộng Bio Sunscreen
- Tẩy tế bào chết 2Clean
- Viên uống chống nắng Bio Sun Care
- Mặt nạ thải độc Bio Sensitive Mask
- Mặt nạ thải độc da Bio Detox Mask
- Sữa rửa mặt dạng gel Bio Multi Cleansing
- Serum đặc trị mụn BSB Solution
- Dầu massage SW-Factor massage oil face and body

Bằng nỗ lực nghiên cứu và ứng dụng công nghệ sinh học đã giúp Geneworld đứng vững trên thị trường mỹ phẩm sinh học và chiếm trọn niềm tin của khách hàng. Bạn có thể tham khảo thêm các sản phẩm Geneworld để có những trải nghiệm đa dạng hơn.
Trên đây là tổng hợp thông tin về công nghệ sinh học là gì và những ứng dụng của công nghệ này trong đời sống cũng như làm đẹp. Đừng quên ghé thăm Geneworld mỗi ngày để có được những thông tin hữu ích nhé!
>>Xem thêm:
Top 10 các hãng mỹ phẩm Organic tốt nhất, nổi tiếng thế giới
Top 11 hãng mỹ phẩm thiên nhiên nổi tiếng và tốt nhất hiện nay
Top 5 mỹ phẩm tế bào gốc cho da tốt nhất hiện nay
Tags: mỹ phẩm organic là gì, organic là gì, mỹ phẩm sinh học là gì, kem chống nắng là gì, kem chống nắng phổ rộng là gì, mặt nạ thiên nhiên, serum dưỡng ẩm, serum tái tạo da, serum tế bào gốc, kem chống nắng organic,...
Bài viết liên quan
1 tuýp kem chống nắng dung tích 50ml dùng được bao lâu?
Cùng một tuýp dung tích 50ml nhưng thời gian sử dụng của mỗi người lại rất khác nhau. Có người vừa mua chưa đầy vài tuần đã dùng gần hết, trong khi người khác lại dùng suốt vài tháng mà sản phẩm vẫ...
Chống nắng vật lý: Cơ chế hoạt động & Cách dùng hiệu quả
Ánh nắng mặt trời là yếu tố môi trường có thể tác động trực tiếp đến sức khỏe làn da mỗi ngày. Tia UV không chỉ khiến da sạm màu mà còn góp phần thúc đẩy quá trình lão hóa sớm và làm suy yếu hàng r...
Review kem chống nắng cho da dầu mụn Sensitive Sunscreen
Nắng nóng, nhiệt độ tăng cao vào mùa hè khô khiến bạn đau đầu khi tình trạng da dầu mụn ngày một tệ hơn: Da đổ nhiều dầu, lỗ chân lông bít tắc và mụn mọc mất kiểm soát. Nếu bạn đang tìm kiếm một sả...